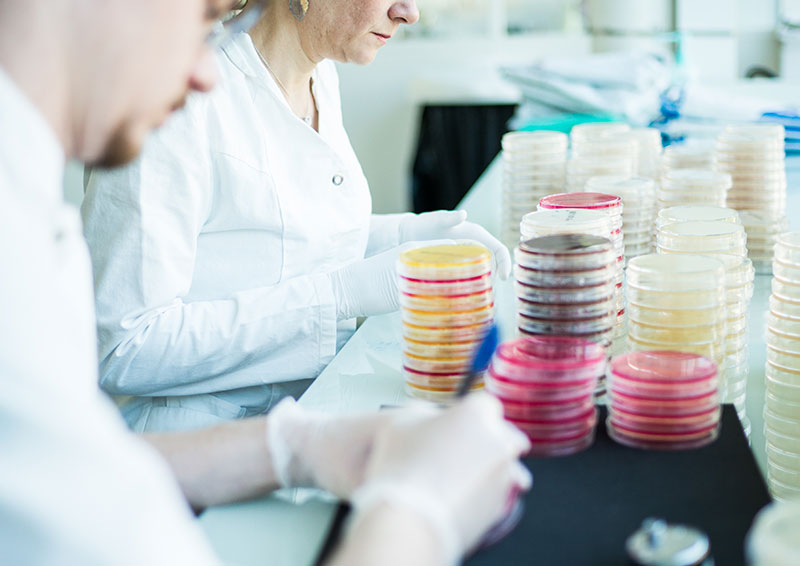
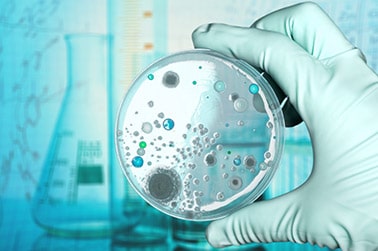

CBI offers a range of infection modeling services for the purposes of identification of novel anti-infective agents, particularly MRSA, vancomycin-resistant staph, fungi and gram positive organisms. In addition to standard infection models, CBI offers customized and unique infection models. We also provide toxicity, safety, in vitro, and pharmacokinetic (including perilymph) studies to support development of anti-infectives. We offer unique routes of administration including intracerebral, intracolonic, intravesicular, intraocular, intraotic, dermal, and intraosseus.
- Mouse protection test
- Neutropenic thigh abscess and cytodex bead abscess
- Bacterial endocarditis in rabbits
- Dermal and topical infection
- Bacterial pneumonia, including Streptococcus and Pseudomonas
- Burn, wound, suture, foreign body implant infection
- Ocular and otic infection
- Oral infection models (food-borne pathogens)
- Renal infection, blood borne and ascending
- Sepsis- LPS, CLP, CASP
- Clostridial diarrhea
- Fungal studies
- Meningitis and bone infection
- Customized infection model development
- Histopathology and special bacterial stains
- Toxicity, safety and pharmacokinetic in vitro studies to support efficacy studies
- Customized and specially licensed cell lines
- Custom bacterial strains
Consultation services in anti-infectives: CBI offers consultation services for anti-infective discovery, efficacy, pharmacokinetics and toxicology as well as regulatory to support our clients’ preclinical programs. Our VP, Dr. James Christenson, is an expert in discovery and development of all types of anti-infectives, including cephalosporins, dual action cephalosporins, MSRA, VRA and other types of anti-infectives. For more information about Dr. Christenson’s anti-infective consultation services please visit his consultation website, or contact our Business Development Team for anti-infectives.
For more information, check out Dr. Carol Meschter’s blog on infection modeling.
